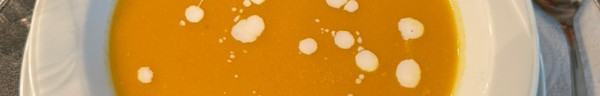

Sobre Cookpad
Nuestra misión en Cookpad es la cocina diaria sea divertida, porque creemos que cocinar es clave para una vida más feliz y saludable para las personas, las comunidades y el planeta. Empoderamos a cocineros caseros de todo el mundo para entre todos nos ayudemos compartiendo sus recetas y experiencias en la cocina.